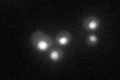
YDL201W
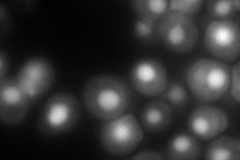
YDL201W
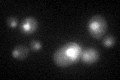
YDL201W

View description
Subunit of a tRNA methyltransferase complex composed of Trm8p and Trm82p that catalyzes 7-methylguanosine modification of tRNA
Localization:
Intensity:
Fold change:
Significance:
-
C’ GFP library in SD
nucleus46.17 -
N' NOP1pr-GFP in SD

nucleus138.111 -
N' TEF2pr-mCherry in SD
nucleus178.606 -
N' NATIVEpr-GFP in SD

nucleus84.7101 -
N' TEF2pr-VC and Cyto-VN in SD

#N/A0 -
C’ GFP library in SD+DTT
nucleus29.570.64Yes -
C’ GFP library in SD+H2O2

nucleus39.250.85No -
C’ GFP library in Starvation Media

nucleus19.410.42Yes -
C’ GFP library on the background of Pup2-DaMP

nucleus -
C’ GFP library on the background of CCT mutant

nucleus42.63170.923245No
